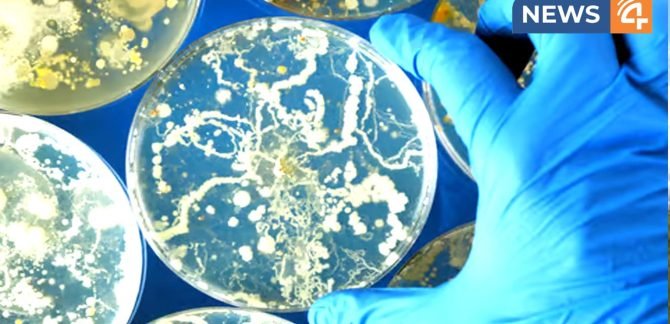

ഫംഗസ്സുകൾ ചിലപ്പോളൊക്കെ അമനുഷ്യർക്ക് ഉപകാരികളാണ്. നാം രുചിയോടെ കഴിക്കുന്ന കൂൺ ഉൾപ്പടെ. എന്നാൽ അങ്ങിനെയല്ലാത്തവയും ഉണ്ട്. ഫംഗസ് മനുഷ്യരാശിക്ക് ഒരു ‘യഥാർത്ഥ ഭീഷണി ആണോ ?’ ആണെന്നു മുന്നറിയിപ്പു നൽകിയിരിക്കുകയാണ് ഗവേഷകർ. മോളിക്യുലർ മൈക്രോബയോളജി, ഇമ്മ്യൂണോളജി, സാംക്രമിക രോഗങ്ങൾ എന്നിവയിൽ ഗവേഷണം നടത്തിവരുന്ന പ്രൊഫസർ അർതുറോ കാസഡെവാൾ ആണ് ഇത്൮ക് സംബന്ധിച്ച പഠനം പുറത്തുവിട്ടത്. തന്റെ ഏറ്റവും പുതിയ പുസ്തകമായ ‘ വാട്ട് ഇഫ് ഫംഗി വിന്’ -ലാണ് പ്രൊഫസർ അർതുറോ ഇതുമായി ബന്ധപ്പെട്ട പരാമർശങ്ങൾ നടത്തിയിരിക്കുന്നത്. … Continue reading മനുഷ്യനെ മുഴുവൻ സോമ്പിയാക്കി, ഭൂമിയിൽ നിന്നും തുടച്ചുനീക്കാൻ ഈ ഫംഗസുകൾക്ക് കഴിയും; മുന്നറിയിപ്പുനൽകി പ്രശസ്ത ഗവേഷകൻ !
0 Comments